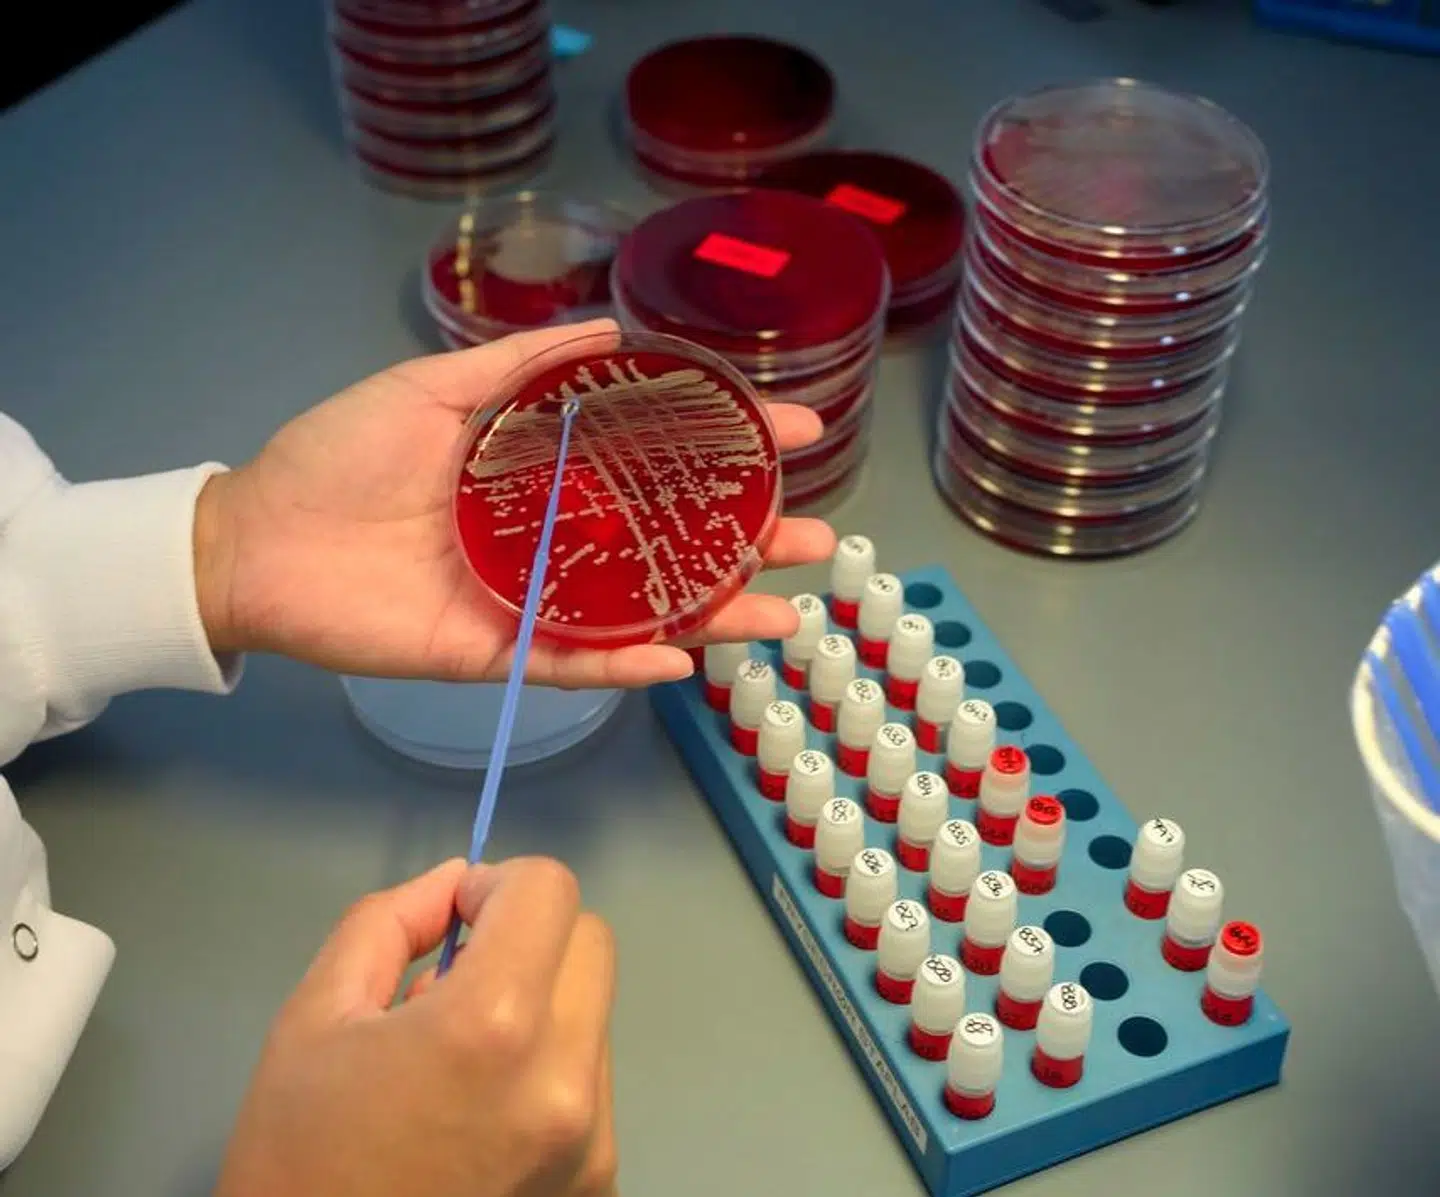
Statens Serum Institut har undladt at informere tre millioner danskere om, at deres biologiske prøver opbevares i Danmarks Nationale Biobank. I en pressemeddelelse 8. april skrev SSI, at danskerne nu ville få besked. Det fremgik dog ikke af SSIs pressemeddelelse, at det var Datatilsynet, som i en principiel afgørelse havde pålagt SSI at give besked.

Staten har i årevis frosset millioner af danskeres blodprøver ned, uden at man har givet danskerne besked.
Det skriver DR.
Det drejer sig om tre millioner danskere, som har fået gemt deres biologiske prøver til brug for forskning. Som bekendt indeholder blodprøver følsomme og personhenførbare oplysninger, fordi de gemmer på personens genetiske data.
8. april, altså for en uge siden, oplyste Statens Serum Institut (SSI) i en nyhed på dets hjemmeside, at man samme dag var begyndt at informere danskerne om opbevaringen. Nyheden blev gennem Ritzau bragt i et stort antal danske medier.
Statens Serum Institut oplyste i den forbindelse, at det »gennem de seneste år« har »arbejdet målrettet på at øge gennemsigtigheden og på at underrette mere om vores behandling af personoplysninger«.
Derfor glædede faglig direktør hos SSI Anne-Marie Vangsted sig over at »tage hul på informationsindsatsen«.
Men SSI undlod at nævne, at beslutningen om at informere danskerne om opbevaringen af deres biologiske materiale ikke skete af egen drift. Det var derimod Datatilsynet, som havde truffet en afgørelse om, at staten skulle give danskerne klar besked, skriver DR.
»Vanskeligt« at kontakte tre millioner borgere via brev
Da Datatilsynet behandlede sagen, argumenterede SSI tilmed imod at sende besked til hver enkelt person, som har blodprøver liggende i biobanken. SSI begyndte først at informere danskere, efter DR begyndte at stille spørgsmål til sagen. Datatilsynets afgørelse faldt ifølge mediet allerede for 14 måneder siden.
Når de tre millioner danskere nu får besked, kan de sende en tak til den 78-årige pensionist Flemming Klein, som undersøgte sagen.
Han anmeldte nemlig ifølge DR sagen til Datatilsynet, efter SSI havde sendt ham en besked om, at Danmarks Nationale Biobank opbevarer 10 millioner biologiske prøver, men at det ville kræve en »uforholdsmæssig« stor indsats at informere hver enkelt borger, hver gang SSI modtog biologisk materiale.
Denne vurdering var Datatilsynet uenig i.
SSI forsvarer sig med, at e-Boks i 2012, da man etablerede biobanken, ikke var så veludviklet.
»Det er korrekt, at vi har haft den her oplysningspligt. Dengang vi startede biobanken i 2012, var e-Boks ikke så veludviklet. Det er vanskeligt at kontakte tre millioner borgere per brev. Nu er det blevet betydeligt lettere at informere. Men jeg synes da også, at vi skulle have gjort det noget før,« lyder det fra Anne-Marie Vangsted, faglig direktør hos SSI, ifølge DR.
Datatilsynet køber ikke helt forklaringen, fordi der er mulighed for at lave automatiserede processer, så informationen af borgere kan glide forholdsvist nemt.